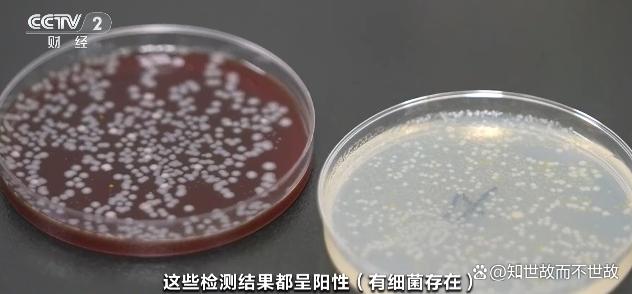

一杯隔夜水惊现透明'果冻虫',竟是摇蚊产下的数百枚卵。这个活生生的惊悚画面让'隔夜水不能喝'的忠告突然具象化,而真相远不止于此——从微生物污染到化学变化,从网友争议到生态价值,这只普通水杯折射出人类与自然的微妙边界。
半透明胶状物在杯底静静躺着,像极了一块迷你果冻,重庆一位女子差点将前晚剩下的隔夜水一饮而尽时,突然发现了这个令人毛骨悚然的“附加物”。
隔夜水不能喝——这个抽象的忠告在2025年10月突然以具象化的形式引爆了网络。重庆一女子准备喝掉前一天晚上剩下的水时,意外发现杯中有一个透明胶状、形似“果冻虫” 的漂浮物。
经验丰富的网友一眼认出,这其实是摇蚊在水中产下的卵。一时间,“隔夜水不要喝”不再是老人毫无根据的唠叨,而是成了眼前活生生的惊悚画面。

01 隔夜水的惊魂记
事件中的女子晚上口渴,倒了一杯水喝了两口,没盖盖子就回房睡觉了。第二天早上准备继续饮用时,突然发现杯中有异样。
起初她以为只是玻璃杯外的污渍,但轻轻一晃,那东西竟然随着水流摆动,质地如同果冻般柔软。
这个看似无害的透明胶状物,在网上被迅速识别为摇蚊卵。一团这样的“果冻”里,常包裹着几百枚摇蚊卵。
摇蚊卵刚产出时被灰色胶质卵鞘包裹,吸水后变成黏性透明的“果冻”,成为未来摇蚊宝宝的第一餐。
02 摇蚊:不咬人的入侵者
与常见的吸血蚊子不同,摇蚊触角浓密如毛刷,口器已经退化,不会叮咬人类,而是以花蜜、花粉为食。
这些看似无害的昆虫分布极广,从北极到南极都有它们的踪迹。
它们爱在水边产卵,不论是自然界的河湖,还是家中的花瓶、鱼缸,甚至是隔夜的水杯,只要有点水就能成为它们的目标。
春夏季节的晨昏,河湖边常出现大群“蚊子”如云盖顶,上下翻飞——这就是摇蚊的“婚飞”奇观。

03 隔夜水的双重风险
微生物污染是没盖盖子的隔夜水的主要风险。水暴露在空气中,会直接接触灰尘、花粉、昆虫等污染物。
空气中的细菌、微生物也在水中繁殖,尤其是在室温下放置超过8小时,细菌数量可能显著增加,饮用后容易引发肠胃不适。
化学变化同样影响水质。隔夜水会吸收空气中的二氧化碳,导致pH值略微下降,口感可能变涩,失去原本的清爽感。
如果使用不合适的容器储存,水中的成分还可能与容器材质发生化学反应,导致金属离子或有害物质析出到水中。
04 杯中之争:喝还是不喝?
面对隔夜水,网友态度两极。有人觉得心惊胆战,表示“再也不敢喝隔夜水”;也有人不以为然,称“以前家里用水缸存水,喝了那么多年也没出问题”。
这两种情况其实不能简单类比。以往的水多是流动水或井水,没经过密封储存,水里氧气充足,不容易滋生虫卵。
而现在家里放的水大多是净化过的自来水,看着干净,反倒更容易成为某些虫子的理想“孵化池”。
有研究显示,隔夜水中的亚硝酸盐含量通常仍在安全范围内,不会致癌。真正的风险来自生物污染,而非化学变化。

05 摇蚊卵的奇幻之旅
被许多人视为恶心污染物的摇蚊卵,在自然界中却扮演着重要角色。
摇蚊幼虫适应力极强,从几周到几年不等的幼虫期里,它们主要吃水底的有机碎屑,起到净化水体的生态功能。
它们几乎占底栖水生生物总量的七八成,为众多水生动物提供天然饵料。甚至有人专门养殖红虫,为水产养殖提供优质饵料。
在非洲维多利亚湖畔,村民还有特殊的捕蚊技巧——在锅内刷一层油,于摇蚊密集处左右挥舞,落入锅中的摇蚊便被油粘住,随后团成肉饼煎熟食用。
这种蚊子饼富含蛋白质,营养价值很高。
06 安全饮水守则
要安全饮用隔夜水,关键在于正确保存。使用干净、密封的容器储存,并尽量减少敞开放置的时间。
将隔夜水存放在阴凉、干燥、通风的地方,避免阳光直射和高温环境。在夏季高温天气或潮湿环境下,可考虑将密封好的水放入冰箱冷藏保存。
如果对隔夜水的安全性存疑,一个简单有效的处理方法是将水重新煮沸,这样可以杀灭大部分细菌。
但对于婴幼儿、老年人或免疫力较弱的人群,建议尽量避免饮用隔夜水。一般情况下,隔夜水的存放时间不要超过24小时。
摇蚊卵在自然环境中本是鱼类的美食,在水杯中却成了令人惊恐的异物。非洲人甚至将摇蚊做成肉饼,视其为蛋白质来源。
而我们却在为杯中的几只摇蚊卵大惊小怪。自然与人类的界限,在一只普通水杯中变得模糊不清。
也许真正值得思考的不是隔夜水能不能喝,而是我们如何与无处不在的自然力量重新相处——即便它只是悄悄潜入了我们夜间的一杯水中。
本文来自于百家号作者:知世故而不世故,仅代表原作者个人观点。本站旨在传播优质文章,无商业用途。如不想在本站展示可联系删除

